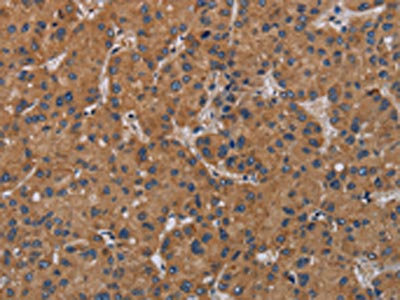

KLK13 Antibody
-
中文名稱:KLK13兔多克隆抗體
-
貨號:CSB-PA374084
-
規格:¥1100
-
圖片:
-
The image on the left is immunohistochemistry of paraffin-embedded Human thyroid cancer tissue using CSB-PA374084(KLK13 Antibody) at dilution 1/20, on the right is treated with fusion protein. (Original magnification: ×200)
-
The image on the left is immunohistochemistry of paraffin-embedded Human liver cancer tissue using CSB-PA374084(KLK13 Antibody) at dilution 1/20, on the right is treated with fusion protein. (Original magnification: ×200)
-
-
其他:
產品詳情
-
Uniprot No.:
-
基因名:KLK13
-
別名:DKFZp586J1923 antibody; Kalikrein antibody; Kallikrein 13 antibody; Kallikrein L4 antibody; Kallikrein Like 4 antibody; Kallikrein like 4 variant included antibody; Kallikrein like gene 4 antibody; Kallikrein like protein 4 antibody; Kallikrein related peptidase 13 antibody; Kallikrein-13 antibody; Kallikrein-like protein 4 antibody; KLK-L4 antibody; KLK13 antibody; KLK13_HUMAN antibody; KLKL 4 antibody; KLKL4 antibody
-
宿主:Rabbit
-
反應種屬:Human
-
免疫原:Fusion protein of Human KLK13
-
免疫原種屬:Homo sapiens (Human)
-
標記方式:Non-conjugated
-
抗體亞型:IgG
-
純化方式:Antigen affinity purification
-
濃度:It differs from different batches. Please contact us to confirm it.
-
保存緩沖液:-20°C, pH7.4 PBS, 0.05% NaN3, 40% Glycerol
-
產品提供形式:Liquid
-
應用范圍:ELISA,IHC
-
推薦稀釋比:
Application Recommended Dilution ELISA 1:2000-1:5000 IHC 1:50-1:200 -
Protocols:
-
儲存條件:Upon receipt, store at -20°C or -80°C. Avoid repeated freeze.
-
貨期:Basically, we can dispatch the products out in 1-3 working days after receiving your orders. Delivery time maybe differs from different purchasing way or location, please kindly consult your local distributors for specific delivery time.
-
用途:For Research Use Only. Not for use in diagnostic or therapeutic procedures.
相關產品
靶點詳情
-
基因功能參考文獻:
- Relatively high levels of KLK13 expression in ESCC were associated with cell proliferation and correlated with tumor progression, advanced cancer stage, and poor prognosis PMID: 29582368
- Decreased KLK13 mRNA levels correlate with poor survival in esophageal squamous cell carcinoma patients. PMID: 29221724
- There was no significant association of KLK13 and KLK14 mRNA expression with the clinical factors ascitic fluid volume or residual tumor mass. In univariate Cox regression analysis, elevated KLK13 mRNA levels were significantly linked with shorter progression-free (PFS; hazard ratio [HR] = 1.97, P = 0.020) and overall survival (OS; HR = 1.81, P = 0.041). PMID: 29546479
- This first clinical study of KLK13 in bladder cancer reveals its deregulated expression in bladder tumors and highlights KLK13 as a promising marker for improving TaT1 patients' prognosis following treatment. PMID: 27858162
- Our results suggest that KLK13 mRNA expression constitutes a novel biomarker for the prediction of overall survival in nonsmall cell lung cancer and that its quantitative assessment in tumor tissues can aid in treatment decision making. PMID: 25677900
- KLK13 may play an important role in regulating cellular migration and invasiveness, making the loss of KLK13 a potential biomarker for early detection of lymph node metastasis in oral squamous cell carcinomas. PMID: 23371469
- Data indicate that five out of 9 SNPs in the KLK13 gene were associated with prostate cancer risk and/or aggressiveness. PMID: 21741862
- High KLK13 expression is associated with drug response in gastric cancer. PMID: 22948777
- Results indicate that KLK13 may play a role in the defense of the upper digestive apparatus and in male reproductive organs. PMID: 21689719
- Serine protease of Kazal-type (SPINK6) expressed in normal human skin is a potent natural inhibitor of Kallikrein-related peptidases, KLK12 and KLK13. PMID: 21439340
- these results reveal the enhancing effects of KLK13 on tumor cell invasion and migration, and that it may serve as a diagnostic/prognostic marker and a potential therapeutic target for lung cancer. PMID: 21596022
- This is the first study disclosing the possible clinical utility of KLK13 as a new tumor biomarker capable of predicting a favorable outcome for gastric cancer patients. PMID: 20678496
- KLK13 expression is an independent favorable prognostic marker for breast carcinoma PMID: 11986781
- kallikrein 13 is expressed in the nonmalignant and malignant prostate, with cancer tissues demonstrating slightly lower expression PMID: 12970725
- hK13 interacts and forms complexes with serum protease inhibitors, including alpha2-macroglobulin, alpha1-antichymotrypsin and alpha2-antiplasmin PMID: 14687906
- Human kallikrein13 may play a role in tissue remodeling and/or tumor invasion and metastasis. PMID: 15381110
- hK13 is expressed in several common salivary gland tumors PMID: 16847813
- non-small-cell lung cancer patients with high KLK13 expression at the mRNA or protein level had lower overall survival PMID: 18627302
- KLK6 and KLK13 predict tumor recurrence in epithelial ovarian carcinoma. PMID: 19707197
顯示更多
收起更多
-
亞細胞定位:Secreted.
-
蛋白家族:Peptidase S1 family, Kallikrein subfamily
-
組織特異性:Expressed in prostate, breast, testis and salivary gland.
-
數據庫鏈接:
Most popular with customers
-
-
YWHAB Recombinant Monoclonal Antibody
Applications: ELISA, WB, IHC, IF, FC
Species Reactivity: Human, Mouse, Rat
-
Phospho-YAP1 (S127) Recombinant Monoclonal Antibody
Applications: ELISA, WB, IHC
Species Reactivity: Human
-
-
-
-
-